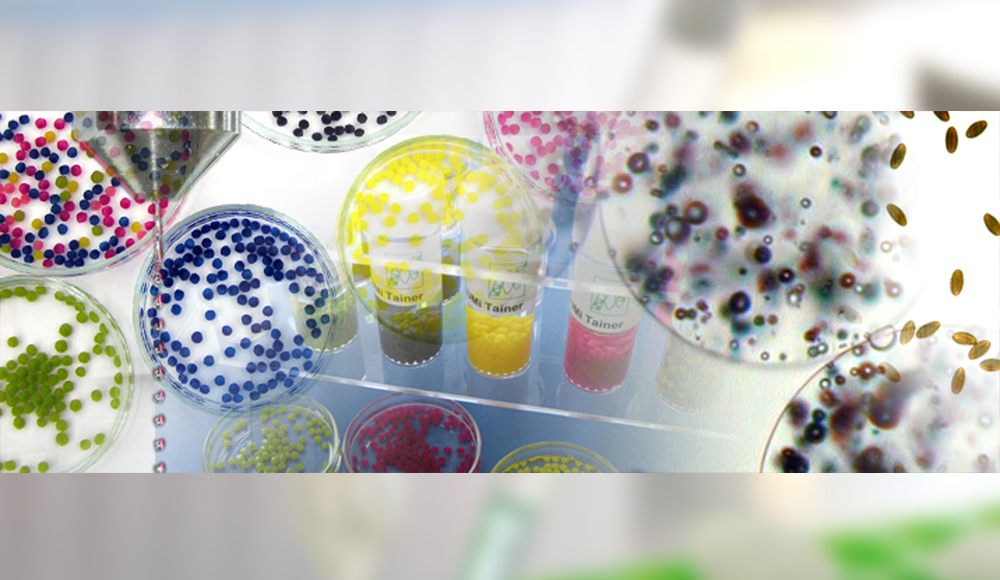

NEUE ANALYTIK
Hansen Solubility Parameters
mittels instrumenteller
Quantifizierung
des Sedimentationsverhaltens
NEUES FORSCHUNGSPROJEKT
ZIM-Kooperationsprojekt
mit der
Philipps-Universität Marburg
zur beschleunigten
Stabilitätsanalyse
von pharmazeutischen
Dispersionen
Auftragsanalytik
Auftragsentwicklung
Referenzmaterialien